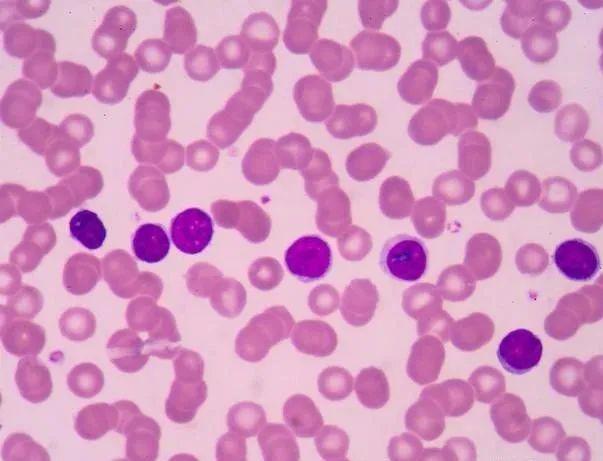

杭州实现重大突破,开启红斑狼疮治疗新篇章。这一突破性进展为红斑狼疮患者带来了新的治疗希望,标志着该领域治疗水平的提升。具体细节尚未公布,但这一成就将有助于推动医学科学的进步,为更多患者带来福音。
本文目录导读:
红斑狼疮,一种复杂的自身免疫性疾病,长久以来困扰着众多患者,在杭州,这一疾病的治疗正迎来重大突破,本文将详细介绍这一突破的背景、过程、影响以及未来展望,以期为红斑狼疮患者带来新的希望。
红斑狼疮的挑战与现状
红斑狼疮是一种涉及多个器官和系统的自身免疫性疾病,其发病原因复杂,临床表现多样,目前,尽管医学界对红斑狼疮的治疗取得了一定的进展,但仍然存在许多挑战,如病情易反复、治疗周期长、副作用大等问题,给患者带来了极大的困扰,在杭州地区,众多患者同样面临着这些挑战,亟需新的治疗方法来改善病情。
杭州实现重大突破:红斑狼疮治疗的新方向
近年来,杭州的医疗团队在红斑狼疮治疗方面取得了重大突破,这一突破主要得益于多学科交叉融合的医疗模式和先进的科研技术,具体而言,杭州的医疗团队通过深入研究红斑狼疮的发病机制,结合先进的生物技术和药物研发,成功开发出一种新型治疗方法。

这种新型治疗方法主要针对红斑狼疮的发病机制,通过调节免疫系统、减轻炎症反应、保护器官功能等多个方面来达到治疗效果,该治疗方法在临床试验中取得了显著的成果,不仅有效控制了病情的反复发作,还显著降低了治疗的副作用。
治疗过程与效果
新型治疗方法的具体过程如下:医生会根据患者的病情制定个性化的治疗方案,通过静脉注射或口服药物的方式给予患者治疗,在治疗过程中,医生会密切关注患者的病情变化,根据实际情况调整治疗方案。
经过一段时间的治疗,患者的病情得到了显著改善,炎症反应得到减轻,器官功能得到保护,病情的反复发作得到了有效控制,治疗的副作用也显著降低,患者的生活质量得到了明显提高。
影响与意义
杭州在红斑狼疮治疗方面实现的这一重大突破,对红斑狼疮患者和社会产生了深远的影响。
对于患者而言,这一突破为他们带来了新的治疗选择,他们不再需要长期忍受病情的反复发作和治疗的副作用,而是可以通过新型治疗方法来改善病情、提高生活质量,这一突破也为患者带来了更多的信心和希望,让他们相信在医学科技的帮助下,他们可以战胜疾病。
对于社会而言,这一突破具有重要的意义,红斑狼疮是一种常见的自身免疫性疾病,影响着众多患者的家庭和社会生活,杭州的这一突破不仅为患者带来了福音,也为社会的和谐稳定做出了贡献,这一突破也展示了杭州地区医疗团队的实力和水平,提高了杭州地区的医疗声誉和影响力。
未来展望
虽然杭州在红斑狼疮治疗方面取得了重大突破,但仍有许多问题需要进一步研究和解决,需要进一步优化治疗方案和过程,提高治疗的效率和安全性,需要加强药物的研发和生产,确保药物的供应和质量,还需要加强患者的教育和管理工作,提高患者的依从性和自我管理能力。
杭州在红斑狼疮治疗方面实现的这一重大突破为患者带来了新的希望和治疗选择,相信在不久的将来,随着医学技术的不断发展和进步,红斑狼疮的治疗将会取得更大的突破和成果。

